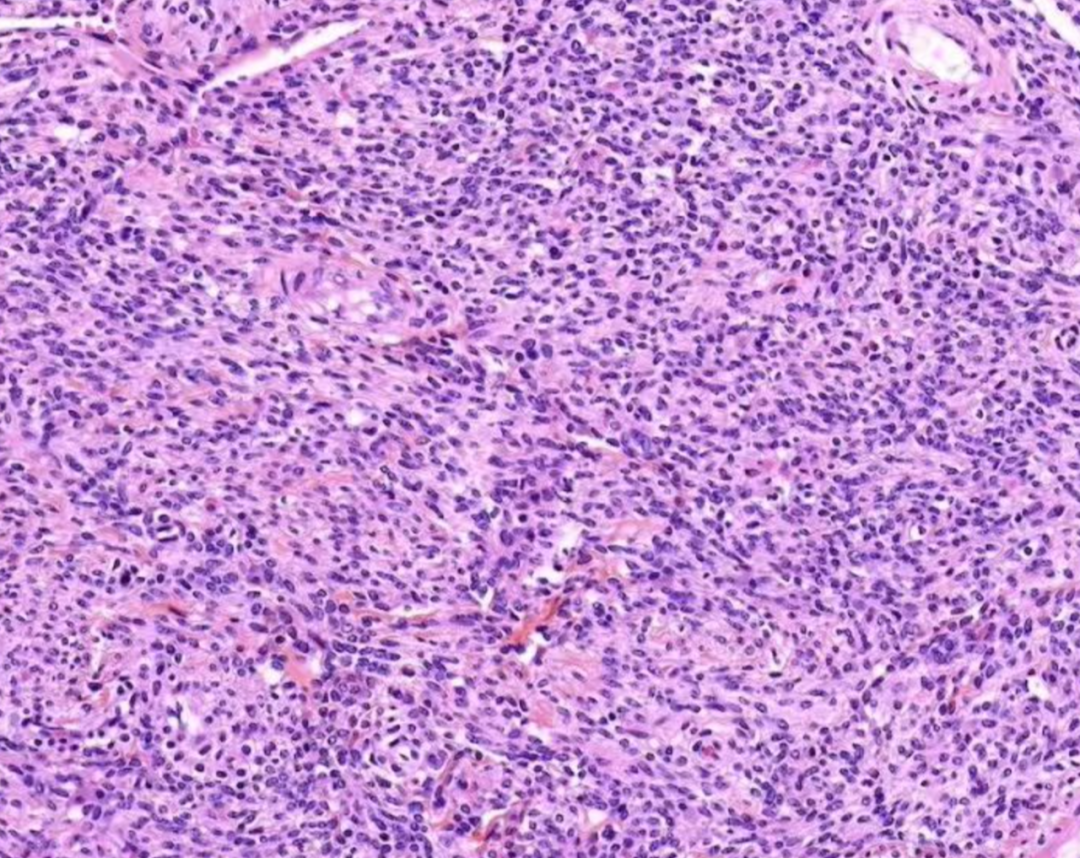

检查出富于细胞型子宫肌瘤,需要紧张吗?
很多女性手术后看到病理报告上写着:“子宫肌瘤(富于细胞型)”
第一反应往往是:
这是不是更严重?
会不会是癌?
是不是容易复发?
要不要马上再治疗?
其实,富于细胞型子宫肌瘤仍然属于良性肌瘤,只是组织结构上有些特殊,容易在检查时引起医生和患者的关注。
结合最新临床认识与病理研究,我们用一篇完整的科普,帮大家真正看懂这个名字背后的含义。
一、什么是富于细胞型子宫肌瘤?
子宫肌瘤是女性最常见的良性肿瘤之一,约 1/3的育龄女性可能存在不同程度的肌瘤。
所谓富于细胞型子宫肌瘤(Cellular Leiomyoma),本质上是:普通子宫平滑肌瘤的一种病理变异类型。
01

普通平滑肌瘤病理
02
富于细胞型平滑肌瘤
显微镜下可以看到:
平滑肌细胞排列更加紧密
细胞数量明显增多
纤维组织相对减少
因此被称为“富于细胞型”。
但要强调:
仍然属于良性肿瘤
不是癌
多数生长行为温和
这种类型约占全部子宫肌瘤的 5%左右,并不罕见。
二、为什么医生会特别关注这种类型?
原因在于:影像表现有时比较“活跃”。
富于细胞型肌瘤:
含水量较高
细胞密度大
血供可能略丰富
在MRI中可能表现为:
信号较普通肌瘤偏高
个别病例增长较快
因此医生在术前检查中往往会更加谨慎,以避免漏诊极少数恶性肿瘤。
但最终多数病例仍然证实为:良性肌瘤。
三、如何最终确诊?病理才是关键
影像只能提示,不能确诊
超声或MRI可以发现:
肌瘤位置
大小
血供情况
生长方式
但不能确定病理类型。
病理检查是“金标准”
病理医生会观察:
细胞密度
是否存在细胞异型
核分裂数量
是否出现肿瘤坏死
富于细胞型肌瘤通常表现为:
细胞多但排列规则
几乎没有异型细胞
核分裂极少
没有坏死
而恶性肿瘤往往会出现:
细胞形态异常
大量分裂
组织坏死
生长紊乱
这两者在显微镜下差异非常明显。
四、与普通子宫肌瘤有什么区别?
对患者来说:症状通常没有明显区别,可能包括:
月经过多
经期延长
贫血
下腹坠胀
尿频
不孕或流产风险增加

五、需要马上治疗吗?
关键不在于类型,而在于:是否有症状?
如果:
肌瘤较小
没有症状
不影响怀孕
通常只需要定期复查即可(6–12个月)。
六、富于细胞型肌瘤会恶变吗?
这是患者最担心的问题。
医学结论是:
恶变极少
恶变率与普通肌瘤接近
富于细胞型并不是癌前病变。医生的谨慎更多是为了避免漏诊。
七、它是否更容易复发?
这一点与普通肌瘤略有不同。部分研究发现:富于细胞型肌瘤术后复发率可能略高,约20%–40%。
原因可能包括:
细胞生长活跃
微小病灶更容易残留
多发肌瘤背景
但这并不代表一定复发。
关键仍在:
手术是否清除彻底
是否规律随访
激素环境管理
八、术后需要怎样随访?
通常建议:
术后第一年:每3–6个月复查一次超声
之后:每年复查一次
年轻、多发肌瘤患者应更加重视随访。

九、给患者的真实建议
如果你拿到报告写着:“富于细胞型子宫肌瘤”
请记住:
它仍然是良性肌瘤
不等于癌
不必过度紧张
关键看症状和生活影响
真正需要关注的是:
是否影响生活
是否影响怀孕
是否持续增大
而不是单纯被名字吓到。
原标题:《富于细胞型子宫肌瘤,需要紧张吗?》

